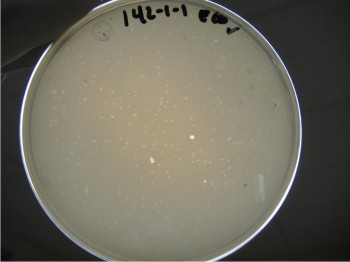

Estas bacterias son las que más afectan las producciones de frutas y hortalizas en Sinaloa
Promoviendo las actividades del proyecto Nuevas alternativas biológicas para la descontaminación de frutas y hortalizas, que Fundación Produce Sinaloa, A.C., apoyó a través de su Consejo Consultivo zona centro, durante el ciclo 2010-2011, se dio a conocer a productores de hortalizas los avances del aislamiento y caracterización de Salmonella y E. coli O157:H7; y se presentaron los avances del aislamiento, caracterización y selección de bacteriófagos específicos de los diversos serotipos de Salmonella y E. coli O157:H7.
Sin tecnología destinada a la descontaminación de hortalizas y frutas, los costos de producción del cultivo de tomate ascienden a 300 mil pesos por hectárea. La producción por hectárea es de 160 toneladas por hectárea t/ha, el precio de la producción por tonelada es de mil 875 pesos. El beneficio bruto es de 900 mil pesos por hectárea; es decir, 5 mil 625 pesos por tonelada. Por lo tanto, la relación beneficio/costo (5625 / 1875) es de 1:3.
Se busca crear un producto para controlar la Salmonella y E. coli
Hasta finales de abril de 2011, 81 cepas fueron serotipificadas: los resultados arrojados mostraron la presencia de 17 serotipos distintos de Salmonella, entre los más de 2 mil reportados por la bibliografía.
Con respecto a E. coli, de las 80 aisladas hasta el momento solo 29 presentan el antígeno O157.
Se cuentan con 35 bacteriófagos aislados de las distintas zonas agrícolas en los municipios de Culiacán, Navolato y Elota.
Hasta el momento, nueve cuentan con potencial para el biocontrol de Salmonella y E. coli, lo cual se traduce en la obtención de un agente biológico para el control de las dos principales bacterias involucradas en brotes asociados al consumo de frutas y hortalizas.
Esto representa una posibilidad tangible de obtener, a mediano plazo, un producto con potencial de control dirigido específicamente a este par de patógenos (que provocan enfermedades) bacterianos que impactan de manera significativa al entorno social y económico del estado.
Identificación, purificación, propagación y selección de bacteriófagos con potencial biotecnológico para el biocontrol de Salmonella y E. coli O157:H7
Se han aislado 35 bacteriófagos en los municipios de Culiacán, Navolato y Elota. Estos bacteriófagos ya han sido aislados, purificados y propagados; se ha iniciado con la determinación del rango de hospederos y, mediante ensayos in vivo, los bacteriófagos aislados han presentado un efecto lítico (que manifiesta un patrón característico) sobre Salmonella y E. coli.
De los 35 bacteriófagos obtenidos con capacidad para destruir los diversos serotipos y/o genotipos de Salmonella y E. coli O157:H7 presentes en la zona centro de Sinaloa, se seleccionaron, con base a sus características biológicas y genéticas, 13 bacteriófagos con potencial biotecnológico para el biocontrol de dichas bacterias (ver Cuadro 1); de estos, se descartaron ocho, debido a la presencia de genes adversos al ambiente; los cinco restantes mostraron ser excelentes candidatos para el control biológico, ya que son distintos, tanto genética como morfológicamente (confieren mayor posibilidad de hacer mezclas que amplíen el efecto de bicontrol sobre más diversidad bacteriana), presentan tamaños de genoma adecuados (son más resistentes a la destrucción por condiciones ambientales), carecen de material genético dañino para el ambiente y las bacterias presentan escasa resistencia.
Es imprescindible mantener la inocuidad de los productos agrícolas frescos para conservar la aceptación en el mercado internacional
El estado de Sinaloa es el principal productor y exportador de hortalizas a nivel nacional. La rentabilidad de los cultivos Sinaloenses está basada, principalmente, en las exportaciones: en la temporada anterior se exportaron alrededor de 317 mil toneladas (t), dejando ganancias para el estado de más de 854 millones de dólares.
Ya que las hortalizas se consumen principalmente frescas, proveen un vehículo de transporte para microorganismos patógenos; debido a ello se han colocado dentro de los cinco principales alimentos asociados a brotes epidemiológicos en Estados Unidos, donde alrededor del 80 % se han atribuido a bacterias como Salmonella, Cyclospora, variedades patógenas de Escherichia coli y Shigella.
Aun cuando los procesos de empacado incluyen la desinfección del fruto, es común la recontaminación a lo largo de la cadena de transporte debido a la vulnerabilidad de las hortalizas para acarrear patógenos. Por tal motivo, se ha recurrido a la búsqueda alternativas de descontaminación que incluyan, además de los desinfectantes químicos que actualmente se utilizan, opciones de protección prolongada a los productos agrícolas frescos y, sobre todo, alternativas de desinfección de productos orgánicos, en los que el uso de productos químicos es restringido.
En este sentido, el control biológico (donde se utilizan microorganismos benéficos, como los bacteriófagos) ofrecen un potencial para la descontaminación de productos frescos. Los bacteriófagos se encuentran ampliamente distribuidos en el ambiente de manera natural y forman parte de la microflora del tracto intestinal de los animales y el hombre; es por ello que no representan un riesgo de enfermedad para los humanos ni animales, y pueden ser considerados una excelente alternativa para utilizarse como descontaminantes de bacterias patógenas.
Información proporcionada por Nohelia Castro del Campo, responsable del proyecto y perteneciente al Centro de Investigación en Alimentación y Desarrollo (CIAD).
Cuadro 1. Bacteriófagos con potencial de biocontrol de Salmonella y E. coli O157:H7 obtenidos en Sinaloa.

- (ausencia de genes adversos)
+ (presencia de genes adversos)